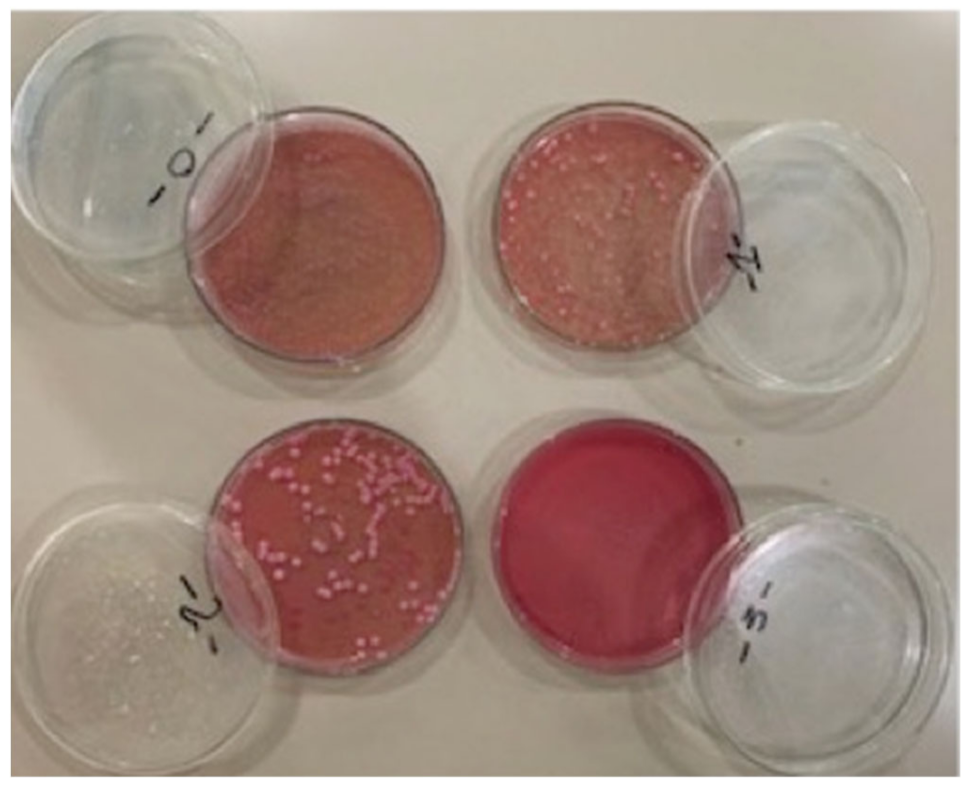
Applsci 12 07004 g004 Applsci 12 07004 g004

Antifungal Efficacy of Sodium Perborate and Microwave Irradiation for Surface Disinfection of Polymethyl Methacrylate Polymer
Abstract
1. Introduction
2. Materials and Methods
2.1. Specimen Preparation
2.2. Study Groups
2.3. Biofilm Formation Assay
2.4. Quantification of Biofilm
2.5. Scanning Electron Microscopy (SEM) Analysis
2.6. Statistical Analysis
3. Results
4. Discussion
5. Conclusions
Author Contributions
Funding
Institutional Review Board Statement
Informed Consent Statement
Data Availability Statement
Acknowledgments
Conflicts of Interest
References
- Hayran, Y.; Sarikaya, I.; Aydin, A.; Tekin, Y.H. Determination of the effective anticandidal concentration of denture cleanser tablets on some denture base resins. J. Appl. Oral Sci. 2018, 26, e20170077. [Google Scholar] [CrossRef] [PubMed]
- Gendreau, L.; Loewy, Z.G. Epidemiology and etiology of denture stomatitis. J. Prosthodont. 2011, 20, 251–260. [Google Scholar] [CrossRef] [PubMed]
- Marsh, P.D.; Percival, R.S.; Challacombe, S.J. The influence of denture-wearing and age on the oral microflora. J. Dent. Res. 1992, 71, 1374–1381. [Google Scholar] [CrossRef] [PubMed]
- Berger, J.C.; Driscoll, C.F.; Romberg, E.; Luo, Q.; Thompson, G. Surface roughness of denture base acrylic resins after processing and after polishing. J. Prosthodont. Implant Esthet. Reconstr. Dent. 2006, 15, 180–186. [Google Scholar] [CrossRef]
- Busscher, H.J.; Weerkamp, A.H.; Van Der Mei, H.C.; Van Pelt, A.W.; De Jong, H.P.; Arends, J. Measurement of the surface free energy of bacterial cell surfaces and its relevance for adhesion. Appl. Environ. Microbiol. 1984, 48, 980–983. [Google Scholar] [CrossRef]
- De Freitas Fernandes, F.S.; Pereira-Cenci, T.; Da Silva, W.J.; Ricomini Filho, A.P.; Straioto, F.G.; Cury, A.A. Efficacy of denture cleansers on Candida spp. biofilm formed on polyamide and polymethyl methacrylate resins. J. Prosthet. Dent. 2011, 105, 51–58. [Google Scholar] [CrossRef]
- Powell, G.L.; Runnells, R.D.; Saxon, B.A.; Whisenant, B.K. The presence and identification of organisms transmitted to dental laboratories. J. Prosthet. Dent. 1990, 64, 235–237. [Google Scholar] [CrossRef]
- Cakan, U.; Kara, O.; Kara, H.B. Effects of various denture cleansers on surface roughness of hard permanent reline resins. Dent. Mater. J. 2015, 34, 246–251. [Google Scholar] [CrossRef][Green Version]
- Yudaev, P.; Chuev, V.; Klyukin, B.; Kuskov, A.; Mezhuev, Y.; Chistyakov, E. Polymeric Dental Nanomaterials: Antimicrobial Action. Polymers 2022, 14, 864. [Google Scholar] [CrossRef]
- Coenye, T.; De Prijck, K.; Nailis, H.; Nelis, H.J. Prevention of Candida albicans Biofilm Formation. Open Mycol. J. 2011, 5, 9–20. [Google Scholar] [CrossRef]
- Yasui, M.; Ryu, M.; Sakurai, K.; Ishihara, K. Colonisation of the oral cavity by periodontopathic bacteria in complete denture wearers. Gerodontology 2012, 29, e494–e502. [Google Scholar] [CrossRef] [PubMed]
- Yatabe, M.; Seki, H.; Shirasu, N.; Sone, M. Effect of the reducing agent on the oxygen-inhibited layer of the cross-linked reline material. J. Oral Rehabil. 2001, 28, 180–185. [Google Scholar] [CrossRef] [PubMed]
- Budtz-Jørgensen, E. Materials and methods for cleaning dentures. J. Prosthet. Dent. 1979, 42, 619–623. [Google Scholar] [CrossRef]
- Shakouie, S.; Milani, A.S.; Eskandarnejad, M.; Rahimi, S.; Froughreyhani, M.; Galedar, S.; Ranjbar, E. Antimicrobial activity of tetraacetylethylenediamine-sodium perborate versus sodium hypochlorite against Enterococcus faecalis. J. Dent. Res. Dent. Clin. Dent. Prospect. 2016, 10, 43–47. [Google Scholar] [CrossRef]
- Fernandes, A.M.; Marques, M.M.; Camargo, S.E.A.; Cardoso, P.E.; Camargo, C.H.R.; Valera, M.C. Cytotoxicity of non-vital dental bleaching agents in human gingival fibroblasts. Braz. Dent. Sci. 2013, 16, 59–65. [Google Scholar] [CrossRef][Green Version]
- Arendorf, T.; Walker, D. Denture stomatitis: A review. J. Oral Rehabil. 1987, 14, 217–227. [Google Scholar] [CrossRef]
- Pavan, S.; Arioli Filho, J.N.; Santos, P.H.d.; Mollo, F.d.A., Jr. Effect of microwave treatments on dimensional accuracy of maxillary acrylic resin denture base. Braz. Dent. J. 2005, 16, 119–123. [Google Scholar] [CrossRef]
- Sanita, P.V.; Vergani, C.E.; Giampaolo, E.T.; Pavarina, A.C.; Machado, A.L. Growth of Candida species on complete dentures: Effect of microwave disinfection. Mycoses 2009, 52, 154–160. [Google Scholar] [CrossRef]
- Campanha, N.H.; Pavarina, A.C.; Brunetti, I.L.; Vergani, C.E.; Machado, A.L.; Spolidorio, D.M.P. Candida albicans inactivation and cell membrane integrity damage by microwave irradiation. Mycoses 2007, 50, 140–147. [Google Scholar] [CrossRef]
- Silva, M.M.; Vergani, C.E.; Giampaolo, E.T.; Neppelenbroek, K.H.; Spolidorio, D.M.; Machado, A.L. Effectiveness of microwave irradiation on the disinfection of complete dentures. Int. J. Prosthodont. 2006, 19, 272–278. [Google Scholar]
- Senna, P.M.; Sotto-Maior, B.S.; da Silva, W.J.; Cury, A.A.D.B. Adding denture cleanser to microwave disinfection regimen to reduce the irradiation time and the exposure of dentures to high temperatures. Gerodontology 2013, 30, 26–31. [Google Scholar] [CrossRef] [PubMed]
- Huda, I.; Nabi, A.T.; Turner, P.S.; Hegde, C. Study to determine and estimate residual monomer leached out in heat cure polymethylmethacrylate Resins of commonly used brands using different polymerization cycles: (An invitro study). IP Ann. Od Prosthodont. Restor. Dentistry 2019, 5, 28–36. [Google Scholar] [CrossRef]
- Najdovski, L.; Dragaš, A.; Kotnik, V. The killing activity of microwaves on some non-sporogenic and sporogenic medically important bacterial strains. J. Hosp. Infect. 1991, 19, 239–247. [Google Scholar] [CrossRef]
- Mirani, Z.; Urooj, S.; Khan, M.; Khan, A.; Shaikh, I.; Siddiqui, A. An effective weapon against biofilm consortia and small colony variants of MRSA. Iran. J. Basic Med. Sci. 2020, 23, 1494–1498. [Google Scholar] [PubMed]
- Haney, E.; Trimble, M.; Cheng, J.; Vallé, Q.; Hancock, R. Critical assessment of methods to quantify biofilm growth and evaluate antibiofilm activity of host defence peptides. Biomolecules 2018, 8, 29. [Google Scholar] [CrossRef]
- Sesma, N.; Rocha, A.L.; Laganá, D.C.; Costa, B.; Morimoto, S. Effectiveness of denture cleanser associated with microwave disinfection and brushing of complete dentures: In vivo study. Braz. Dent. J. 2013, 24, 357–361. [Google Scholar] [CrossRef]
- Dantas, A.; Consani, R.L.X.; Sardi, J.; Mesquita, M.; Silva, M.; Sinhoreti, M. Biofilm formation in denture base acrylic resins and disinfection method using microwave. J. Res. Pract. Dent. 2014, 2014, 112424. [Google Scholar] [CrossRef][Green Version]
- Al-Saadi, M.H. Effectiveness of chemical and microwave disinfection on denture biofilm fungi and the influence of disinfection on denture base adaptation. J. Indian Prosthodont. Soc. 2014, 14, 24–30. [Google Scholar] [CrossRef]
- Arita, M.; Nagayoshi, M.; Fukuizumi, T.; Okinaga, T.; Masumi, S.; Morikawa, M.; Kakinoki, Y.; Nishihara, T. Microbicidal efficacy of ozonated water against Candida albicans adhering to acrylic denture plates. Oral Microbiol. Immunol. 2005, 20, 206–210. [Google Scholar] [CrossRef]
- Anaraki, M.R.; Mahboubi, S.; Pirzadeh, T.; Lotfipour, F.; Torkamanzad, N. Disinfection effect of microwave radiation on Bacillus subtilis as indicator organism on contaminated dental stone casts under dry and wet conditions. GMS Hyg. Infect. Control 2017, 12, 294. [Google Scholar]
- Banik, S.; Bandyopadhyay, S.; Ganguly, S. Bioeffects of microwave—A brief review. Bioresour. Technol. 2003, 87, 155–159. [Google Scholar] [CrossRef]
- Mese, A.; Mese, S. Effect of Microwave Energy on Fungal Growth of Resilient Denture Liner Material. Biotechnol. Biotechnol. Equip. 2007, 21, 91–93. [Google Scholar] [CrossRef][Green Version]
- Tarbet, W.J. Denture plaque: Quiet destroyer. J. Prosthet. Dent. 1982, 48, 647–652. [Google Scholar] [CrossRef]
- Dills, S.; Olshan, A.; Goldner, S.; Brogdon, C. Comparison of the antimicrobial capability of an abrasive paste and chemical-soak denture cleaners. J. Prosthet. Dent. 1988, 60, 467–470. [Google Scholar] [CrossRef]
- Webb, B.C.; Thomas, C.J.; Harty, D.W.; Willcox, M. Effectiveness of two methods of denture sterilization. J. Oral Rehabil. 1998, 25, 416–423. [Google Scholar] [CrossRef] [PubMed]
- Polyzois, G.L.; Zissis, A.J.A.; Yannikakis, S. The effect of glutaraldehyde and microwave disinfection on some properties of acrylic denture resin. Int. J. Prosthodont. 1995, 8, 150–154. [Google Scholar] [PubMed]
- Neppelenbroek, K.; Pavarina, A.C.; Spolidorio, D.M.P.; Vergani, C.E.; Mima, E.G.D.O.; Machado, A.L. Effectiveness of microwave sterilization on three hard chairside reline resins. Int. J. Prosthodont. 2003, 16, 264–270. [Google Scholar]
- Drake, D.; Wells, J.; Ettinger, R. Efficacy of denture cleansing agents in an in vitro bacteria-yeast colonization model. Int. J. Prosthodont. 1992, 5, 300–307. [Google Scholar]
- Ferreira, M.F.; Pereira-Cenci, T.; De Vasconcelos, L.M.R.; Rodrigues-Garcia, R.C.M.; Cury, A.A.D.B. Efficacy of denture cleansers on denture liners contaminated with Candida species. Clin. Oral Investig. 2009, 13, 237–242. [Google Scholar] [CrossRef]
- Heikal, M.M.A.; Nabi, N.A.; Elkerdawy, M.W. A study comparing patient satisfaction and retention of CAD/CAM milled complete dentures and 3D printed CAD/CAM complete dentures versus conventional complete dentures: A randomized clinical trial. Braz. Dent. Sci. 2022, 3, 25. [Google Scholar] [CrossRef]

| Growth Time & Exposure Time vs. Control | Control CFU | MW-DC-DW | MW + DW | DC + DW |
|---|---|---|---|---|
| 96 h | 1400 | MD (p-value) | MD (p-value) | MD (p-value) |
| 1 min | −429 (0.008 **) | −197 (0.008 **) | −94 (0.008 **) | |
| 2 min | −447 (0.008 **) | −300 (0.008 **) | −98 (0.008 **) | |
| 3 min | −1388 (0.007 **) | −1344 (0.008 **) | −98 (0.007 **) | |
| 4 min | −1388 (0.008 **) | −1344 (0.008 **) | −200 (0.008 **) | |
| 5 min | −1388 (0.008 **) | −1344 (0.008 **) | −750 (0.008 **) |
Publisher’s Note: MDPI stays neutral with regard to jurisdictional claims in published maps and institutional affiliations. |
© 2022 by the authors. Licensee MDPI, Basel, Switzerland. This article is an open access article distributed under the terms and conditions of the Creative Commons Attribution (CC BY) license (https://creativecommons.org/licenses/by/4.0/).
Share and Cite
Choudhry, Z.; Malik, S.; Mirani, Z.A.; Khan, S.A.; Kazmi, S.M.R.; Farooqui, W.A.; Ahmed, M.A.; AlAali, K.A.; Alshahrani, A.; Alrabiah, M.; et al. Antifungal Efficacy of Sodium Perborate and Microwave Irradiation for Surface Disinfection of Polymethyl Methacrylate Polymer. Appl. Sci. 2022, 12, 7004. https://doi.org/10.3390/app12147004
Choudhry Z, Malik S, Mirani ZA, Khan SA, Kazmi SMR, Farooqui WA, Ahmed MA, AlAali KA, Alshahrani A, Alrabiah M, et al. Antifungal Efficacy of Sodium Perborate and Microwave Irradiation for Surface Disinfection of Polymethyl Methacrylate Polymer. Applied Sciences. 2022; 12(14):7004. https://doi.org/10.3390/app12147004
Chicago/Turabian StyleChoudhry, Ziaullah, Sofia Malik, Zulfiqar A. Mirani, Shujah A. Khan, Syed M. R. Kazmi, Waqas A. Farooqui, Muhammad A. Ahmed, Khulud A. AlAali, Abdullah Alshahrani, Mohammed Alrabiah, and et al. 2022. "Antifungal Efficacy of Sodium Perborate and Microwave Irradiation for Surface Disinfection of Polymethyl Methacrylate Polymer" Applied Sciences 12, no. 14: 7004. https://doi.org/10.3390/app12147004
APA StyleChoudhry, Z., Malik, S., Mirani, Z. A., Khan, S. A., Kazmi, S. M. R., Farooqui, W. A., Ahmed, M. A., AlAali, K. A., Alshahrani, A., Alrabiah, M., Albaqawi, A. H., & Abduljabbar, T. (2022). Antifungal Efficacy of Sodium Perborate and Microwave Irradiation for Surface Disinfection of Polymethyl Methacrylate Polymer. Applied Sciences, 12(14), 7004. https://doi.org/10.3390/app12147004

